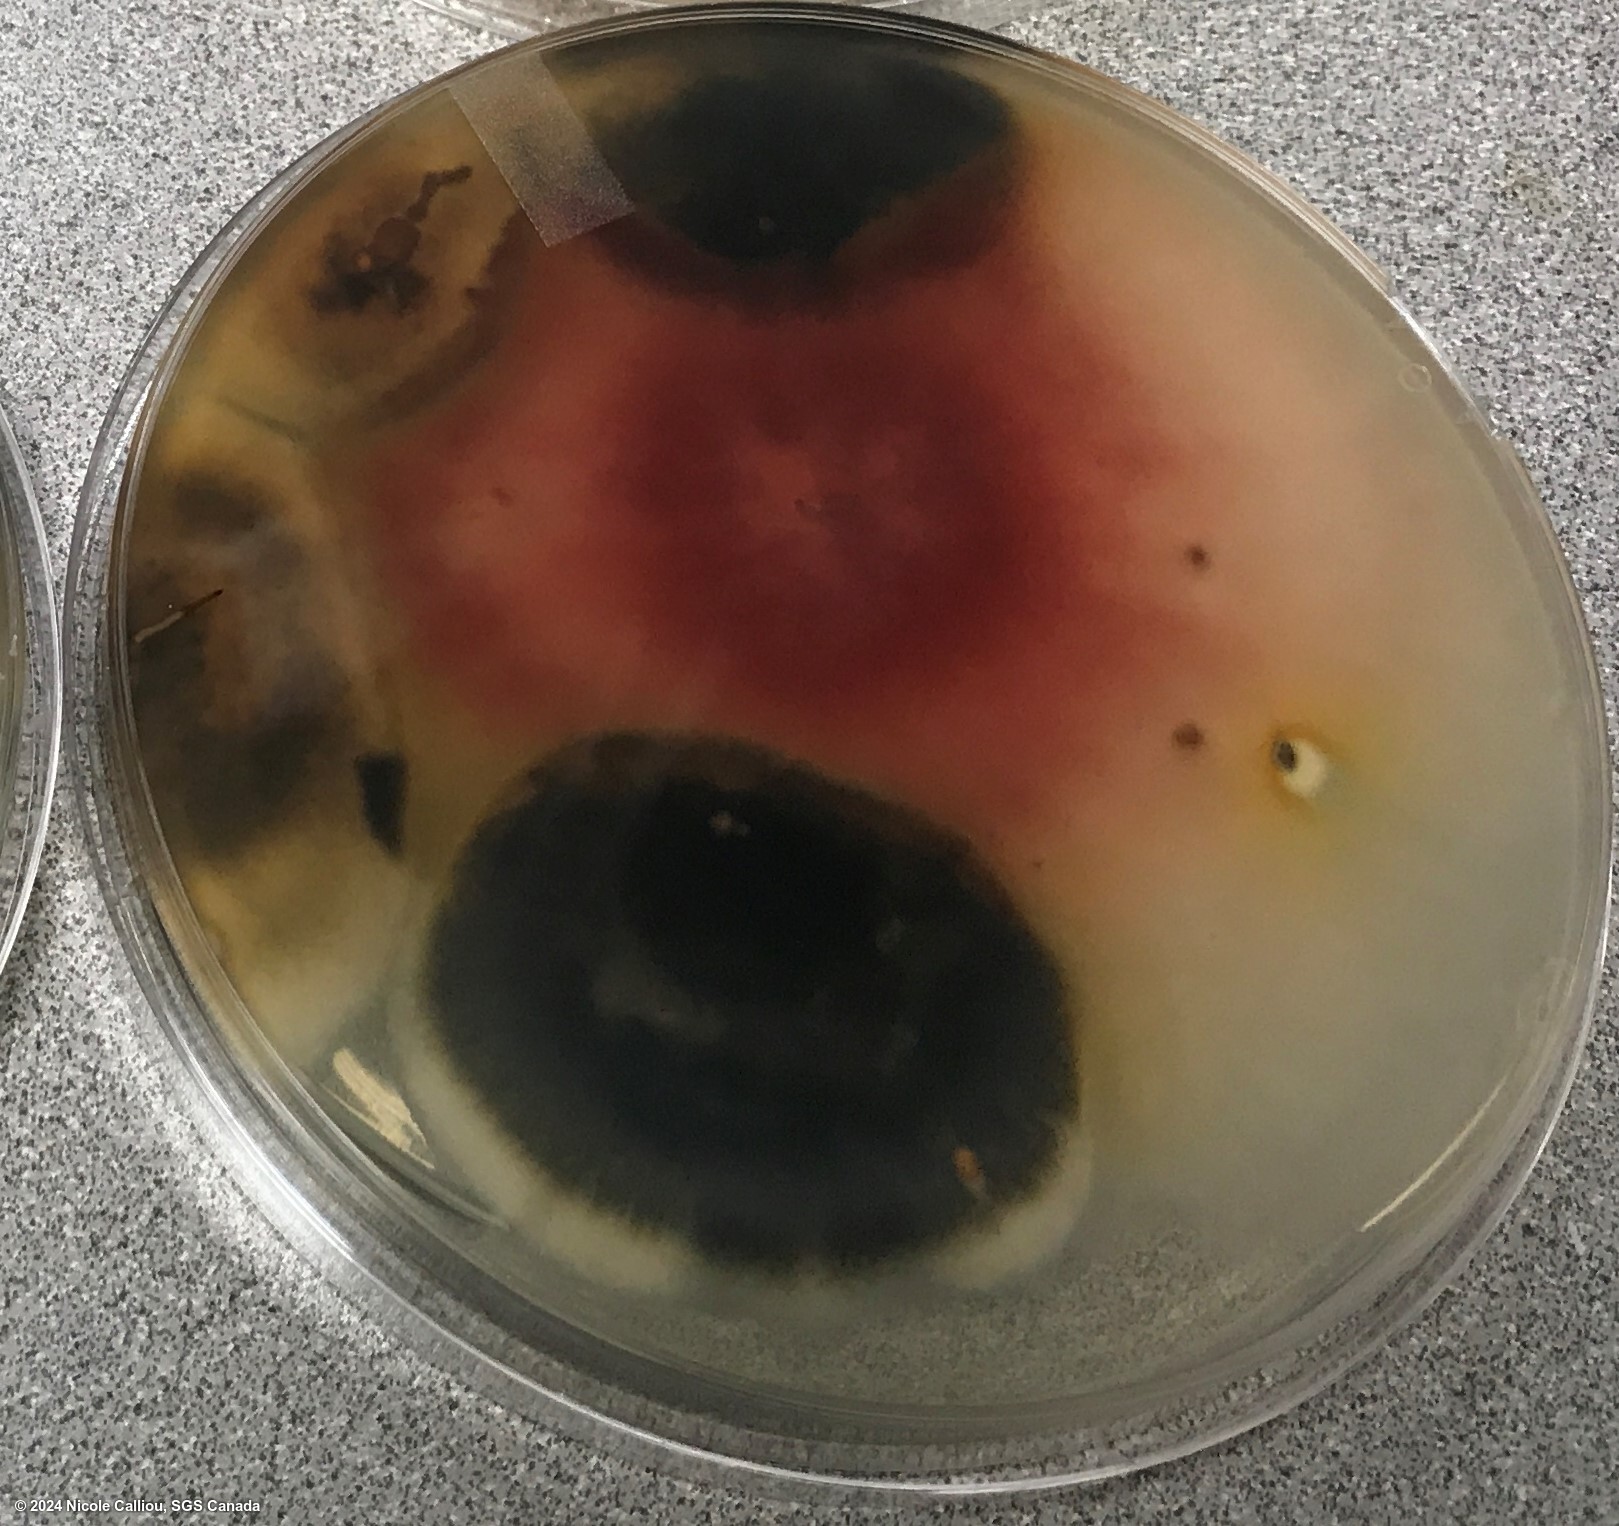

Fusarium graminearum
Overview
|
Scientific name
|
Fusarium graminearum |
|
Genus
|
Fusarium |
|
EPPO code
|
GIBBZE |
|
Common name
|
Fusarium Head Blight |
|
Synonyms
|
Gibberella zeae |
Description
Colony is often described as 'salmon pink' on PDA, but can range from light pink to dark red (also described as 'carmine red'). The red pigments in the agar are pH sensitive, and may turn yellow over time as the pH drops. The mycelium will lie more flat at the center of the colony, and rise higher near the actively growing edges. Colony is typically classified as 'fast' growing, and should be at least 4-7cm wide by day 5 of growth (may be larger, but some colonies may have restricted growth).
On malt agar, mycelium is abundant and aerial, pink coloured and white to yellow on the aerial part of the mycelium. Sporodochia are orange and concentrated in the center of the colony.
Sporodochia (orange to red-brown) may be formed if grown near nUV light, and the macroconidia should be very distinct. They will be canoe-shaped or naviculate, with a relatively shallow bend in the middle with the ends bending sharply. One end will have a very distinct foot cell, and the other will be softly pointed. Usually 5-6 septate, and the septa should be quite distinct. Microconidia are absent.
Conidiophores: unbranched and branched monophialides.
Chlamydospores are rare, formed in the macroconidia or the mycelium.
15 Adon Fusarium graminearum is less virulent, produces fewer spores, and less DON than 3 Adon Fusarium graminearum. A DNA test is best to differentiate these.
From ISTA's Common Laboratory Seed Health Testing Methods for Detecting Fungi:
Presence of loose, white to pinkish mycelium on seed, having bunches of white shiny conidia and orange to pinkish, slimy pionnotes interspersed in the mycelium or below the mycelium. When the mycelium is removed, a scarlet red colour may be seen in the mycelium, and on the seed surface.